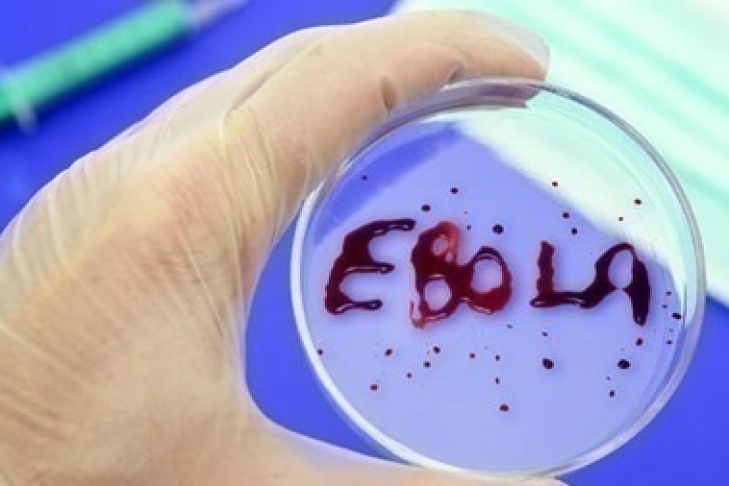

Четыре человека умерли от Эболы в Гвинее
Пока неизвестно, как именно заразились погибшие
Новая вспышка лихорадки Эбола в западноафриканской Гвинее унесла жизни четырех человек, сообщил Национальный координационный центр по борьбе с Эболой, сообщает Корреспондент.net.
Умерла девушка, госпитализированная в лечебно-исследовательский центр Эболы в префектуре Нзерекоре.
Еще три человека скончались в период с 29 февраля. Пока неизвестно, как именно заразились погибшие.
Ранее Всемирная организация здравоохранения (ВОЗ) подтвердила два случая заражения лихорадкой Эбола в западноафриканской Гвинее. Вирус был выявлен у двух человек в Гвинее несколько часов спустя после заявления ВОЗ об окончании вспышки Эболы в соседней Сьерра-Леоне и о прекращении распространения вируса в Западной Африке.
По данным Всемирной организации здравоохранения (ВОЗ), в результате эпидемии БВВЭ в Западной Африке погибли более 11 тысяч человек. Большинство жертв пришлось на три страны – Гвинею, Сьерра-Леоне и Либерию. Вспышка смертельно опасного вируса оставила сиротами 22 тысяч детей.





 Общество «Хімічний зашморг Кремля: як олігарх Фірташ тримає в заручниках український агросектор та суди»
Общество «Хімічний зашморг Кремля: як олігарх Фірташ тримає в заручниках український агросектор та суди»  Политика «В ЕС заявили, что Приднестровье не помешает вступлению Молдовы в Евросоюз»
Политика «В ЕС заявили, что Приднестровье не помешает вступлению Молдовы в Евросоюз»  Общество «20-річний киянин отримав 7 років і 6 місяців за спробу теракту зі скутером»
Общество «20-річний киянин отримав 7 років і 6 місяців за спробу теракту зі скутером»  Общество «Музейні колекції без належного захисту: фондосховища досі не збудовані»
Общество «Музейні колекції без належного захисту: фондосховища досі не збудовані»  Политика «Коаліція 17 держав, посилення позицій України у Східному Середземномор’ї та перезапуск відносин з Кіпром: результати роботи посла Сергія Ніжинського»
Политика «Коаліція 17 держав, посилення позицій України у Східному Середземномор’ї та перезапуск відносин з Кіпром: результати роботи посла Сергія Ніжинського»  Общество «Глава Минобороны Украины назвал условия увольнения военнослужащих, проходящих службу с 2022 года»
Общество «Глава Минобороны Украины назвал условия увольнения военнослужащих, проходящих службу с 2022 года»